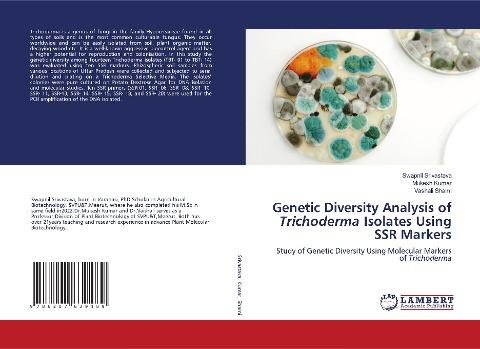
Genetic Diversity Analysis of Trichoderma Isolates Using SSR Markers

Autorenfreundlich Bücher kaufen?!

Beschreibung
Study of Genetic Diversity Using Molecular Markers of Trichoderma
Details
| Verlag | LAP LAMBERT Academic Publishing |
| Ersterscheinung | 02. Mai 2024 |
| Maße | 22 cm x 15 cm x 0.7 cm |
| Gewicht | 185 Gramm |
| Format | Softcover |
| ISBN-13 | 9786207639489 |
| Seiten | 112 |
